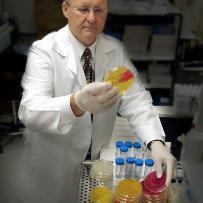
Profile picture

Leslie Garry Adams
Doctorate
-
Texas A and M UniversityCollege Station, United States
